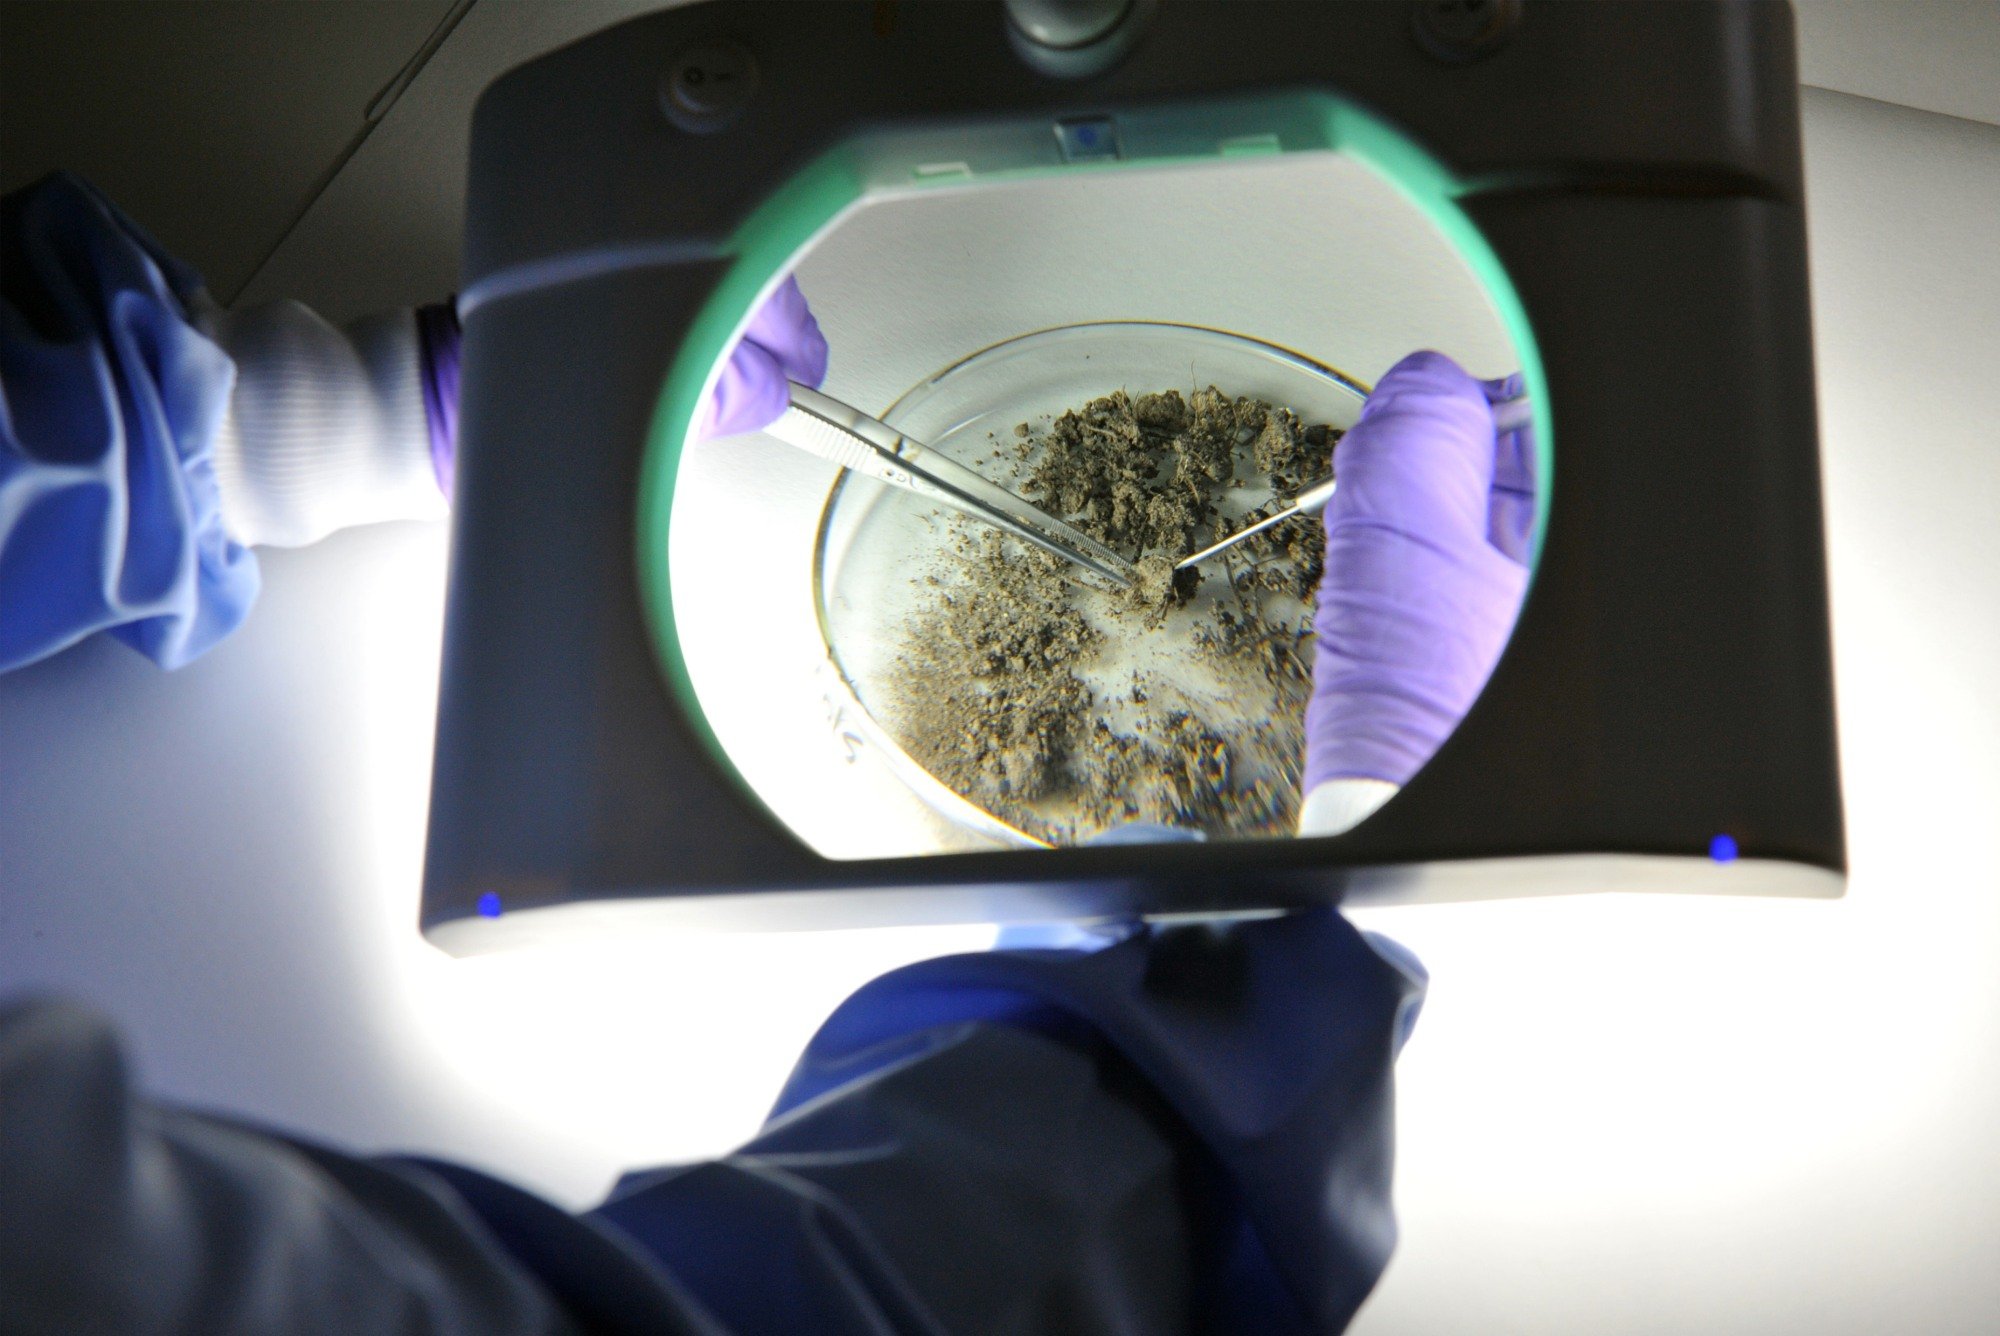

Hutton Soils
Soil Analysis
The Hutton Soils analysis, provided through James Hutton Limited, service offers high quality soil analysis in our accredited laboratories to help you manage your soil effectively. Whether you are a farmer, gardener or groundsman the condition of your soil is critical to successful cultivation.
Why
We determine soil fertility and pH to enable urban highly managed soil to be managed effectively. Minimising possible fertiliser usage and ensuring good soil management.
What
Soil fertility, pH & organic matter are determined to enable gardeners and allotment holders to manage their soil effectively and maximise yield. Whilst managing artificial inputs.


How
Sample kits are ordered on our website. Soil samples are sent to our laboratory using a FreePost service. Analysts analyse the soil using accredited techniques and report data in an easy-to-understand format via e-mail.
A tailored service to suit your needs
Don't need the fine toothcomb service? No problem, we offer three levels of analytical package
Package 1
£130
Some key features
-
Lorem ipsum dolor sit amet, consectetur
-
Lorem ipsum dolor sit amet, consectetur
-
Lorem ipsum dolor sit amet, consectetur
Package 2
£100
Some key features
-
Lorem ipsum dolor sit amet, consectetur
-
Lorem ipsum dolor sit amet, consectetur
-
Lorem ipsum dolor sit amet, consectetur
Package 3
£70
Some key features
-
Lorem ipsum dolor sit amet, consectetur
-
Lorem ipsum dolor sit amet, consectetur
-
Lorem ipsum dolor sit amet, consectetur
No fuss. No delays. Just premium quality.
Independent
Quality Assured (ISO 17025)
Fast
15 days - efficient analysis and reporting
Results
Report emailed and or posted direct to you
How to prepare your soil sample
Watch our video on preparing your soil sample for testing
"Lorem ipsum dolor sit amet, consectetur adipiscing elit. Duis accumsan velit sit amet sagittis malesuada."